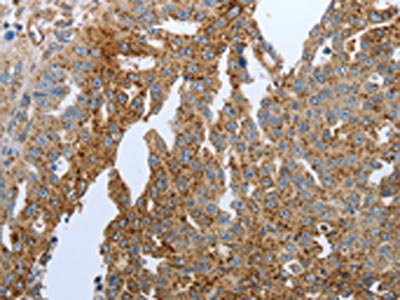

PPARG Antibody
-
中文名稱:PPARG兔多克隆抗體
-
貨號:CSB-PA053064
-
規格:¥1100
-
圖片:
-
The image on the left is immunohistochemistry of paraffin-embedded Human ovarian cancer tissue using CSB-PA053064(PPARG Antibody) at dilution 1/20, on the right is treated with synthetic peptide. (Original magnification: ×200)
-
The image on the left is immunohistochemistry of paraffin-embedded Human thyroid cancer tissue using CSB-PA053064(PPARG Antibody) at dilution 1/20, on the right is treated with synthetic peptide. (Original magnification: ×200)
-
-
其他:
產品詳情
-
Uniprot No.:
-
基因名:
-
別名:CIMT1 antibody; GLM1 antibody; NR1C3 antibody; Nuclear receptor subfamily 1 group C member 3 antibody; OTTHUMP00000185032 antibody; OTTHUMP00000185036 antibody; Peroxisome proliferator activated nuclear receptor gamma variant 1 antibody; Peroxisome proliferator activated receptor gamma 1 antibody; Peroxisome Proliferator Activated Receptor gamma antibody; Peroxisome proliferator-activated receptor gamma antibody; PPAR gamma antibody; PPAR-gamma antibody; PPARG antibody; PPARG_HUMAN antibody; PPARG1 antibody; PPARG2 antibody; PPARgamma antibody
-
宿主:Rabbit
-
反應種屬:Human,Mouse
-
免疫原:Synthetic peptide of Human PPARG
-
免疫原種屬:Homo sapiens (Human)
-
標記方式:Non-conjugated
-
抗體亞型:IgG
-
純化方式:Antigen affinity purification
-
濃度:It differs from different batches. Please contact us to confirm it.
-
保存緩沖液:-20°C, pH7.4 PBS, 0.05% NaN3, 40% Glycerol
-
產品提供形式:Liquid
-
應用范圍:ELISA,IHC
-
推薦稀釋比:
Application Recommended Dilution ELISA 1:1000-1:5000 IHC 1:25-1:100 -
Protocols:
-
儲存條件:Upon receipt, store at -20°C or -80°C. Avoid repeated freeze.
-
貨期:Basically, we can dispatch the products out in 1-3 working days after receiving your orders. Delivery time maybe differs from different purchasing way or location, please kindly consult your local distributors for specific delivery time.
-
用途:For Research Use Only. Not for use in diagnostic or therapeutic procedures.
相關產品
靶點詳情
-
功能:Nuclear receptor that binds peroxisome proliferators such as hypolipidemic drugs and fatty acids. Once activated by a ligand, the nuclear receptor binds to DNA specific PPAR response elements (PPRE) and modulates the transcription of its target genes, such as acyl-CoA oxidase. It therefore controls the peroxisomal beta-oxidation pathway of fatty acids. Key regulator of adipocyte differentiation and glucose homeostasis. ARF6 acts as a key regulator of the tissue-specific adipocyte P2 (aP2) enhancer. Acts as a critical regulator of gut homeostasis by suppressing NF-kappa-B-mediated proinflammatory responses. Plays a role in the regulation of cardiovascular circadian rhythms by regulating the transcription of ARNTL/BMAL1 in the blood vessels.; (Microbial infection) Upon treatment with M.tuberculosis or its lipoprotein LpqH, phosphorylation of MAPK p38 and IL-6 production are modulated, probably via this protein.
-
基因功能參考文獻:
- LEPR rs1137101 and PPARG-2 rs1801282 had weak and medium negative effects on zBMI, respectively, and may slightly protect against childhood obesity. PMID: 29679223
- Data show the partial-agonist-bound PPARgamma is characterized by multiple thermodynamically accessible conformations. PMID: 29728618
- Cellular metabolism constrains innate immune responses in preterm infants due to perturbations in the expression of PPARgamma, MALT1, DDIT4, and most of the cytokines. PMID: 30446641
- PPARgamma knockdown resulted in increased levels of TOMM40, APOE and APOC1 -mRNAs, showing the strongest impact on APOE transcript levels. PMID: 28065845
- Studies indicate that peroxisome proliferator activated receptor gamma (PPARgamma) expression is found in different regions of the kidney and, upon activation, can redirect metabolism [Review]. PMID: 30012954
- These results demonstrate that betaine acts through ERK1/2-PPARgamma signalling pathway to regulate lipid metabolism in adipogenic-differentiated skeletal muscle cells, which could provide some useful information for controlling muscle lipid accumulation by manipulating ERK1/2 and PPARgamma signalling pathway. PMID: 29383561
- novel soluble form present in maternal plasma, umbilical plasma, and amniotic fluid, elevated in gestational diabetes mellitus maternal individuals, and correlated with the lipid uptake of trophoblast cells PMID: 28720051
- ALDH1A3 suppression could be one of PPARG tumor suppressive function. This study provides a better understanding of the role of PPARG in lung cancer. PMID: 29873276
- Regulation of transmembrane-4-L-six-family-1 (TM4SF1) on bladder cancer cell could be induced by peroxisome proliferator-activated receptor gamma (PPARgamma)-sirtuin 1 (SIRT1) feedback loop. PMID: 29175458
- Peroxisome proliferators-activated receptor gamma polymorphism is associated with the risk of colorectal cancer. PMID: 29970681
- The lack of PPARγ in recurrent miscarriage decidual macrophages seems to be associated with a specific inflammatory response against the fetus. PMID: 29949879
- EDF1 is required for VEGF-induced activation of the transcriptional activity of PPARgamma in HUVEC cells. PMID: 29933613
- Studied peroxisome proliferator-activated receptor-gamma gene (PPARgamma) single nucleotide polymorphisms (SNPs); found the SNPs to be associated with the occurrence or progression of sepsis. PMID: 29055064
- This study suggests that T2D patients with different genotypes at CD36, NOS3 and PPARG respond differentially to intervention of omega-3 supplements in blood lipid profiles. PMID: 29703528
- ITLN1, PPARg AND TNFa GENE EXPRESSION IN VISCERAL ADIPOSE TISSUE. PMID: 30188100
- Gene expressions of YKL-40 and CD36 were significantly higher in patients with T2DM (>5 yr) with hypertension compared to healthy controls (P=0.006). In addition, a significant increase in serum levels of sCD36, PPAR-gamma and YKL-40 was observed in patients with T2DM (>5 yr) with hypertension compared to healthy controls PMID: 29806605
- Mechanistic investigation revealed a miR-301b~miR-130b-PPARgamma axis, whose expression pattern in umbilical cord (UC), adipose tissue (Ad) and bone marrow mesenchymal stem cells significantly correlates with their adipogenic capacity. PMID: 28442776
- The negative responders for aerobic training are subjects with the PPARG rs1801282 Pro/Pro genotype. The best responders to aerobic training are PPARG rs1801282 Ala carriers. PMID: 29762540
- These results demonstrated the association of PPARgamma Pro allele with susceptibility to acne vulgaris. PMID: 29120856
- participation rates in the genotype-based recall study were 31%, 44%, and 40%, and accordingly we included 12, 15, and 13 individuals with Pro12Pro, Pro12Ala, and Ala12Ala variants of PPARG, respectively PMID: 29303622
- Here we have shown for the first time, that ligand- or insulin-mediated activation of PPARgamma in human hepatoma cell line HepG2 causes the downregulation of C3 gene expression and protein secretion PMID: 29550264
- Interactions between SOD2 and PPAR-gamma SNPs regarding mortality influence were detected in diabetic ESRD patients. PMID: 27925431
- Data suggest that up-regulation of NPY inhibits proliferation of adipose-derived stem cells while promoting adipogenesis and up-regulating expression of white adipocyte biomarkers PPARG, CEBPA, CIDEC, and RIP140. (NPY = neuropeptide Y; CEBPA = CCAAT/enhancer-binding protein alpha; CIDEC = cell death-inducing DFFA-like effector C; RIP140 = nuclear receptor interacting protein 1) PMID: 28954935
- The presence of Pro12Pro and C14131C genotypes is related to higher TAG level in CTD. PMID: 29606859
- Low PPARG expression is associated with childhood obesity. PMID: 28733963
- The results propose that PPARgamma may act as a master regulator of the transcription of several genes involved in late-onset Alzheimer's disease pathogenesis. PMID: 29723294
- Polymorphism of PPARG is associated with late onset of type 2 diabetes mellitus. PMID: 28292576
- PPARgamma gene rs2921190 polymorphism was correlated with the susceptibility to northwest dryness syndrome. PMID: 29960292
- Phosphorylation of S273 of PPARgamma occurs in cancer cells on exposure to DNA damaging agents. PMID: 29295932
- Chinese Han persons with C allele of rs3856806 in PPARG gene were significantly associated with the decreased risk of hypertension. PMID: 29266977
- We further identified this underlying mechanism also involved a PPARgamma-induced ANXA1-dependent autoubiquitination of cIAP1, the direct E3 ligase of RIP1, shifting cIAP1 toward proteosomal degradation..our study provides first insight for the suitability of using drug-induced expression of ANXA1 as a new player in RIP1-induced death machinery in triple-negative breast cancer PMID: 29021293
- PAX8-PPARG fusions may not play major roles in the tumorigenesis of paediatric follicular thyroid carcinoma PMID: 28621837
- Quantitative polymerase chain reaction, immunohistochemistry, Western blotting, and microarray analysis showed enrichment of adipogenic mediators (C/EBP family P = .027; KLF5 P < .000; and peroxisome proliferator activated receptor-gamma, P = .032) in AAA tissue. PMID: 28912007
- the mRNA expression levels of PPARG were not significantly different between the tumor tissues and tissue margins PMID: 28504924
- These results suggest that the inhibited brain development seen in humans exposed to the stress of a premature extrauterine environment is modulated by genetic factors, and that PPARG signaling has a previously unrecognized role in cerebral development. PMID: 29229843
- PPAR-gamma and Akt regulate GLUT1 and GLUT3 surface localization during Mycobacterium tuberculosis infection. PMID: 28852964
- Here, the authors characterize mutant RXRA, demonstrating it induces enhancer/promoter activity in the context of RXRA/PPAR heterodimers in human bladder cancer cells. PMID: 29143738
- Low PPARG expression is associated with Gemcitabine Resistance in Cholangiocarcinoma. PMID: 28560603
- PPARG gene polymorphism causes the development of oxidative stress in patients with type 2 diabetes with 5-10 years durations. PMID: 29762970
- co-expression of PPARgamma and TRAP220 represents a biomarker for good prognosis in colorectal cancer patients PMID: 26130665
- Carriers of the PPAR-gamma Ala12 allele showed greater cognitive decline compared to non-carriers but the risk varied across sex and ethnic groups. Male Ala12 carriers of Hispanic origin may be a high-risk group for cognitive decline. PMID: 28181642
- overexpression of GATA3 and FOXA1 cooperate with PPAR activation to drive transdifferentiation of a basal bladder cancer cells to a luminial phenotype. PMID: 27924948
- Results show that the nuclear distribution of PPARgamma in gastric cancer (GC) tissues and cell lines was markedly decreased. Its expression is regulated by miR-133b in gastric neoplasm tissue and cell lines. PMID: 28901466
- study implies that DJ-1 may protect endothelial progenitor cells against Ang II-induced dysfunction by activating the PPARgamma/HO-1. PMID: 28600848
- There were no differences between the distribution of genotypes and the allele frequencies of the PPARG Pro12Ala, and C1431T polymorphisms and the ADRB3 Trp64Arg polymorphism in normo- and hyperglycaemic women. PMID: 29464546
- We conclude that rs1784933 and rs1805192 minor alleles, gene- gene interaction between rs1784933 and rs1805192, gene- environment interaction between rs1784933 and alcohol drinking, and haplotype containing the rs1784933- A and rs689021- C alleles are all associated with increased LOAD risk. PMID: 28427149
- Most of the tested flavonoids, but not the antioxidant vitamins, stimulated Nrf2-, FoxO-, and PPARgamma-dependent promoter activities. PMID: 28761622
- Findings suggest that despite their proposed involvement in the regulation of inflammatory processes in multiple sclerosis (MS), PPARalpha, PPARbeta/delta, and PGC-1alpha proteins are not potential biomarkers of neuroinflammation in MS, and indicate a preferential role of PPARgamma in the endogenous regulation of autoimmune response in the human central nervous system within its receptor family. PMID: 28483651
- combined administration of small-interfering RNA (siRNA) transfection with PPARgamma ligands induced downregulation of SOX2 and MMP2 activity together with inhibition of sphere-forming activity regardless of poly(ADP-ribose) polymerase (PARP) cleavage. Taken together, our findings suggest that a combination therapy using PPARgamma ligands and its inhibitor could be a potential therapeutic strategy targeting glioblastom... PMID: 28642874
- Results showed that polymorphism in PPARGrs10865710, PPARGrs1805192 and CYP1A1rs4646903 and interaction between PPARGrs1805192 and CYP1A1rs4646903 were related with increased coronary artery disease susceptibility. PMID: 28415751
顯示更多
收起更多
-
相關疾病:Obesity (OBESITY); Lipodystrophy, familial partial, 3 (FPLD3); Glioma 1 (GLM1)
-
亞細胞定位:Nucleus. Cytoplasm. Note=Redistributed from the nucleus to the cytosol through a MAP2K1/MEK1-dependent manner. NOCT enhances its nuclear translocation.
-
蛋白家族:Nuclear hormone receptor family, NR1 subfamily
-
組織特異性:Highest expression in adipose tissue. Lower in skeletal muscle, spleen, heart and liver. Also detectable in placenta, lung and ovary.
-
數據庫鏈接:
Most popular with customers
-
-
YWHAB Recombinant Monoclonal Antibody
Applications: ELISA, WB, IHC, IF, FC
Species Reactivity: Human, Mouse, Rat
-
Phospho-YAP1 (S127) Recombinant Monoclonal Antibody
Applications: ELISA, WB, IHC
Species Reactivity: Human
-
-
-
-
-